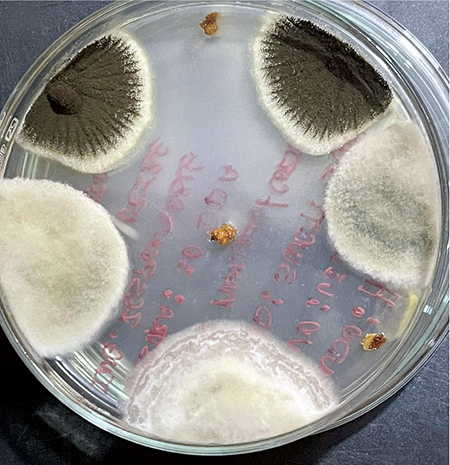

Quillibrium: biopesticida para el control de botrytis en uva y arándano
El crecimiento agrícola es sin duda uno de los principales motores de la economía peruana. Para continuar contribuyendo con el país, el sector debe continuar adaptándose y respondiendo a las exigencias de un mercado que demanda eficiencia y cumplimiento de determinadas obligaciones, como la reducción de residuos químicos.

En sintonía con las tendencias globales de una agricultura más sostenible y respetuosa del medio ambiente, Syngenta Crop Protection, a través de su socio Tecnología Química y Comercio (TQC), incorpora en su portafolio el nuevo biopesticida Quillibrium. Se trata de un fungicida biológico a base de extracto de Quillay que permitirá a los productores peruanos de uva y arándano controlar la podredumbre gris o botrytis, una de las enfermedades más importante reportadas en el Perú.
“Como Syngenta siempre estamos desarrollando programas fitosanitarios que, además de incluir un portafolio de productos consolidados en el mercado, incorporan soluciones innovadoras como Quillibrium. El producto permite cosechas inmediatas post aplicación, esto debido a que está exento de residuos. Además, constituye una herramienta clave para reducir la carga química y evitar la resistencia o tolerancia de productos químicos. De esa forma, los productores podrán garantizar que sus envíos de fruta lleguen a destino sin ningún inconveniente”, indica Pompeyo Gamboa, Key Account Specialist de Syngenta.

La compañía Botanical Solutions recurrió a los avances en biotecnología para elaborar la solución Quillibrium. La producción de plántulas de Quillaja saponaria se realizó de manera in vitro en un laboratorio, hasta lograr una biomasa gracias a un proceso patentado por la compañía de biotecnología. Posteriormente, se extrajo diversos compuestos fenólicos, los cuales son responsables de las principales acciones fungicidas. Todo el esquema de producción es amigable con el medio ambiente, ya que para su realización no se talaron árboles.
Este proceso de producción asegura la misma carga genética y químicamente idéntica a la de la materia prima, a diferencia de otros extractos botánicos que no se enfocan en detalles como la calidad de sus materias primas y la consistencia de sus ingredientes activos. Quillibrium asegura esta consistencia y respaldo de la calidad de su formulación, cada litro trae la misma carga activa para ejercer el control necesario en campo bajo las recomendaciones de etiqueta.
Quillibrium es un fungicida natural con acción multisitio, lo cual hace que no genere resistencias. Dentro de sus mecanismos de acción contra los hongos, actúa inhibiendo la germinación de conidias y micelio de los hongos, además inhibe el desarrollo de enzimas relacionadas con la patogénesis, las infecciones iniciales, el ciclo infectivo y la defensa contra desarrollo de hongos necrotróficos, tales como Botrytis spp.

Estudios recientes a cargo del destacado Doctor en Biotecnología, Gustavo Zuñiga, y su equipo, demostraron que Quillibrium induce la respuesta del mecanismo de defensa natural de las plantas (SAR) a través del aumento de la síntesis de hormonas del estrés, regulando positivamente los genes relacionados con la patogenia (PR), generando así la síntesis de compuestos antimicrobianos, incluidas la fitoalexinas, y produciendo especies reactivas de oxígeno (ROS).
Fernando Roca, R&D Syngenta, destaca como las principales características de Quillibrium su consistencia y eficacia para el control de Botrytis y de otras enfermedades y hongos post cosecha. Al ser un producto con efecto multisitio, no genera resistencia y posee efecto SAR, además su formulación no deja mancha. Dicho efecto ha comprobado en el arándano, fruto que mantiene el Bloom tras la aplicación de la solución. El producto tiene certificación orgánica, por ende posee 0 días de PHI, y cuenta con acceso a todos los mercados.
“Quillibrium está registrado en los cultivos de vid, arándanos y fresa para el control de Botrytis y Oidio (vid), estamos trabajando en las próximas ampliaciones para que ataque enfermedades asociadas a pudriciones sobre frutos. Urge una herramienta que ayude a los productores a hacer frente a las exigencias del mercado internacional”, señala Pompeyo Gamboa, Key Account Specialist de Syngenta.
En Perú, el área técnica de Syngenta y TQC ha desarrollado más de 30 ensayos en los cultivos de uva, arándano, y fresa; entregando un alto performance de control y estabilidad en todas las zonas del norte y sur del país donde se ha testeado los productos.
En los ensayos de arándano se observa un performance bastante alto de Quillibrium, donde el mayor valor es el mantenimiento del Bloom y no manchado de los frutos.
Contactos: